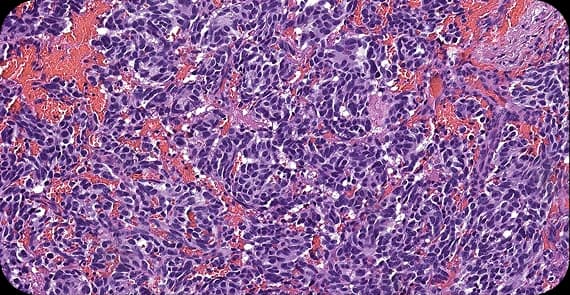
Neuroendocrine Tumours

Pancreatic Cancer
Pancreatic Cancer Treatment in India
A diagnosis of pancreatic cancer can be particularly serious because the pancreas plays a vital role in digestion and blood sugar regulation. Pancreatic cancer develops when abnormal cells grow uncontrollably within the pancreas, often progressing silently in its early stages.
Alongside conventional approaches such as surgery, chemotherapy, radiation therapy, targeted therapy, and immunotherapy, many patients explore complementary and alternative medicine (CAM) approaches as supportive care to improve strength, immune balance, and overall well-being during treatment.
Diagnosed with pancreatic cancer? Dr. Tarang offers personalised, integrative treatment planning grounded in clinical oncology experience.
What Is Pancreatic Cancer?
When patients ask what pancreatic cancer is, the explanation begins at the cellular level. Pancreatic cancer occurs when cells in the pancreas develop genetic mutations that cause uncontrolled growth and division.
The pancreas has both digestive and hormonal functions. What happens in pancreatic cancer is the gradual transformation of healthy pancreatic cells into malignant cells that can invade nearby blood vessels and organs. Because the pancreas is located deep in the abdomen, early tumours may not produce obvious symptoms.
Understanding how pancreatic cancer develops helps explain why early detection can be challenging.
Types of Pancreatic Cancer
There are different types of pancreatic cancer depending on the cells from which the tumour arises.
The most common type, originating in the ducts that carry digestive enzymes.
Arise from hormone-producing cells and may behave differently from adenocarcinomas.
Include cystic tumours and acinar cell carcinomas.
What Are the Symptoms of Pancreatic Cancer?
Pancreatic cancer symptoms are often subtle in the early stages.
Common Signs and Symptoms of Pancreatic Cancer
Abdominal or back pain
Jaundice, causing yellowing of the skin and eyes
Unexplained weight loss
Loss of appetite
Nausea or vomiting
New-onset diabetes
Fatigue
Early pancreas cancer symptoms may be mild or nonspecific. Some patients search for pancreas cancer symptom variations due to vague digestive complaints. Recognising pancreatic cancer symptoms early and seeking evaluations can be critical.
Causes of Pancreatic Cancer
Patients often ask why pancreatic cancer happens. The exact cause is usually multifactorial.
What causes pancreatic cancer may include:
Genetic mutations
Chronic pancreatitis
Smoking
Obesity
Long-standing diabetes
Family history of pancreatic cancer
The reasons behind pancreatic cancer typically involve long-term cellular damage and genetic susceptibility.
Risk Factors for Pancreatic Cancer
Several factors increase the likelihood of developing pancreatic cancer.
Common risk factors include:
Smoking
Chronic inflammation of the pancreas
Obesity
Diabetes
Increasing age
Family history
While these factors increase risk, not all individuals with risk factors develop the disease.
Pancreatic Cancer Stages Explained
Pancreatic cancer stages describe how far the tumour has spread.
Stage I
Cancer confined to the pancreas.
Stage II
Spread to nearby tissues or lymph nodes.
Stage III
Involvement of major blood vessels near the pancreas.
Stage IV
Metastatic pancreatic cancer that has spread to distant organs such as the liver or lungs.
Staging is essential for determining appropriate pancreatic cancer treatment strategies.
How Is Pancreatic Cancer Diagnosed?
Pancreatic cancer diagnosis involves imaging and tissue confirmation.
The diagnostic process may include:
CT scan or MRI
Endoscopic ultrasound
Biopsy of suspicious tissue
Blood tests, including tumour markers
PET imaging in selected cases
Accurate diagnosis allows for stage-specific and personalised treatment plans.
Pancreatic Cancer Treatment Options
Pancreatic cancer treatment depends on stage, tumour location, and overall patient health.
Common pancreatic cancer treatments include:
Surgery: Removes the tumour, sometimes through complex procedures such as pancreatic resection.
Chemotherapy: Uses anti-cancer drugs to destroy rapidly dividing cells.
Radiation therapy: Uses high-energy beams to target cancer cells.
Targeted therapy: Focuses on specific genetic or molecular features of cancer cells.
Immunotherapy: Stimulates the immune system to recognise and attack cancer cells.
Early-stage disease may be treated surgically, while advanced stages often require systemic therapy. Support during chemotherapy is particularly important to maintain strength.
CTA: Complex pancreatic cancer cases need tailored care. Dr. Tarang integrates standard and supportive therapies into personalised plans.
Explore Integrative Cancer Treatment Options
Integrative and CAM-Centric Approach to Pancreatic Cancer Care
Alongside conventional pancreatic cancer treatment, integrative supportive care may improve overall wellbeing. The Cancer Healer Therapy Program combines complementary and alternative medicine with evidence-based oncology care.
This approach may include:
Immune support during chemotherapy
Blood sugar regulation support
Stress management and mind-body techniques
Carefully supervised herbal or traditional medicine components
Personalised therapy planning aligned with medical treatment
The aim is to strengthen the body during intensive pancreatic cancer treatments without replacing evidence-based therapy.
Is Pancreatic Cancer Curable?
Many patients ask whether pancreatic cancer is curable. The answer depends largely on the stage at diagnosis.
National and Global Statistics
Pancreatic cancer is among the more aggressive gastrointestinal cancers worldwide. In India, its incidence is increasing, partly due to lifestyle and metabolic factors.
Curability Insights
Early-stage pancreatic cancer confined to the pancreas may be treated surgically.
Locally advanced disease often requires combined therapies.
Metastatic pancreatic cancer may require long-term systemic treatment strategies.
Early detection remains challenging, which is why awareness of pancreatic cancer symptoms is important.
Frequently Asked Questions About Pancreatic Cancer
Pancreatic cancer symptoms may include abdominal pain, jaundice, unexplained weight loss, and fatigue.